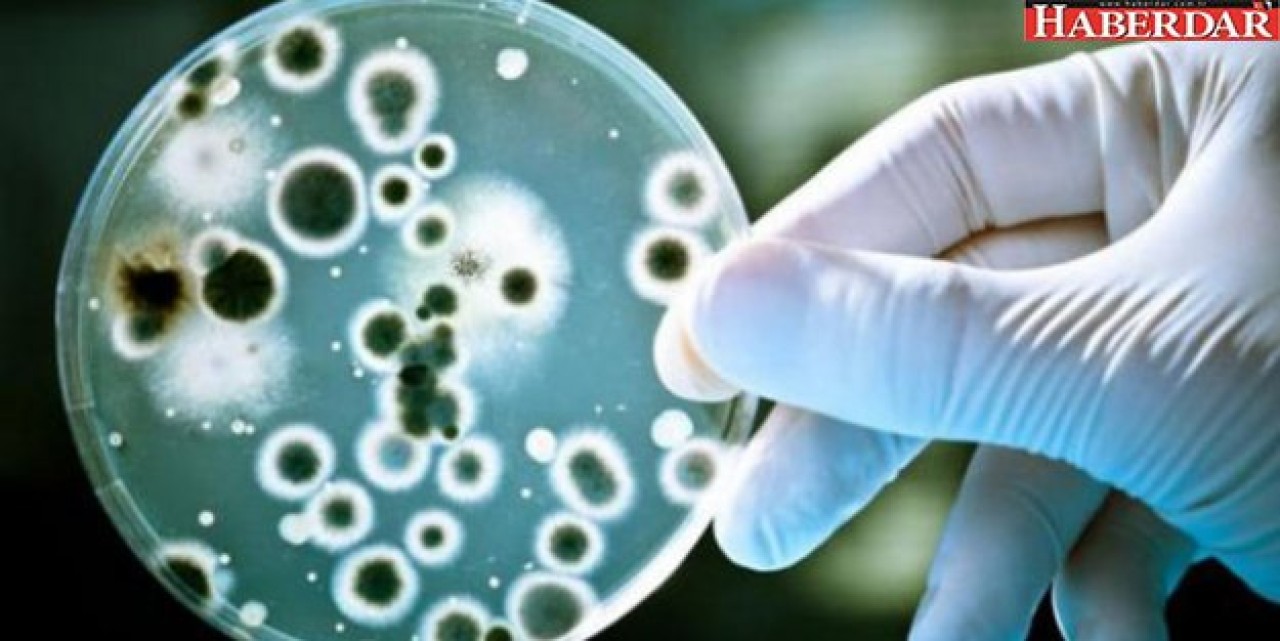
Korkutan keşif: Tedavisi yok

Avrupa'da ortaya çıkan süper bakteri türünün küresel olarak yayıldığı belirtildi.
Avustralya'nın Melbourne Üniversitesinden bilim adamları, staphylococcus epidermidis adlı bakterinin farklı antibiyotik formlarına toplu direnç geliştiren çeşitleri olduğunu tespit etti.
Avrupa'da ortaya çıkan süper bakteri türünün küresel olarak yayıldığı belirtildi. Avustralya'da 2012 yılında bir hastada görülen süper bakteri hakkında 6 yıldır çalışmalar yürüten Dr. Jean Lee, söz konusu bakterinin, rifampicin ve vancomycin türü antibiyotiklere dirençli olduğunu kaydetti.
TEDAVİ SEÇENEĞİ YOK
Bu iki antibiyotik türünün birbirine alternatif tedaviler olduğunu ifade eden araştırmacılar, her iki türe direnç geliştiren süper bakterinin tedavi seçeneklerini tükettiğine dikkati çekti.
Lee, antibiyotik direncinin bazı hallerde tedavi edilemez noktaya ulaştığına işaret etti.
10 ÜLKE 78 NOKTA
Hastane enfeksiyonlarına da neden olan süper bakterinin 10 ülkede 78 sağlık merkezinde görüldüğü belirtildi.
Araştırmacılar, aşırı ve kontrolsüz antibiyotik kullanımının bakterileri ilaçlara giderek daha bağışık hale getirdiği uyarısında bulundu.
Araştırmanın sonuçları "Nature Microbiology" dergisinde yayımlandı.